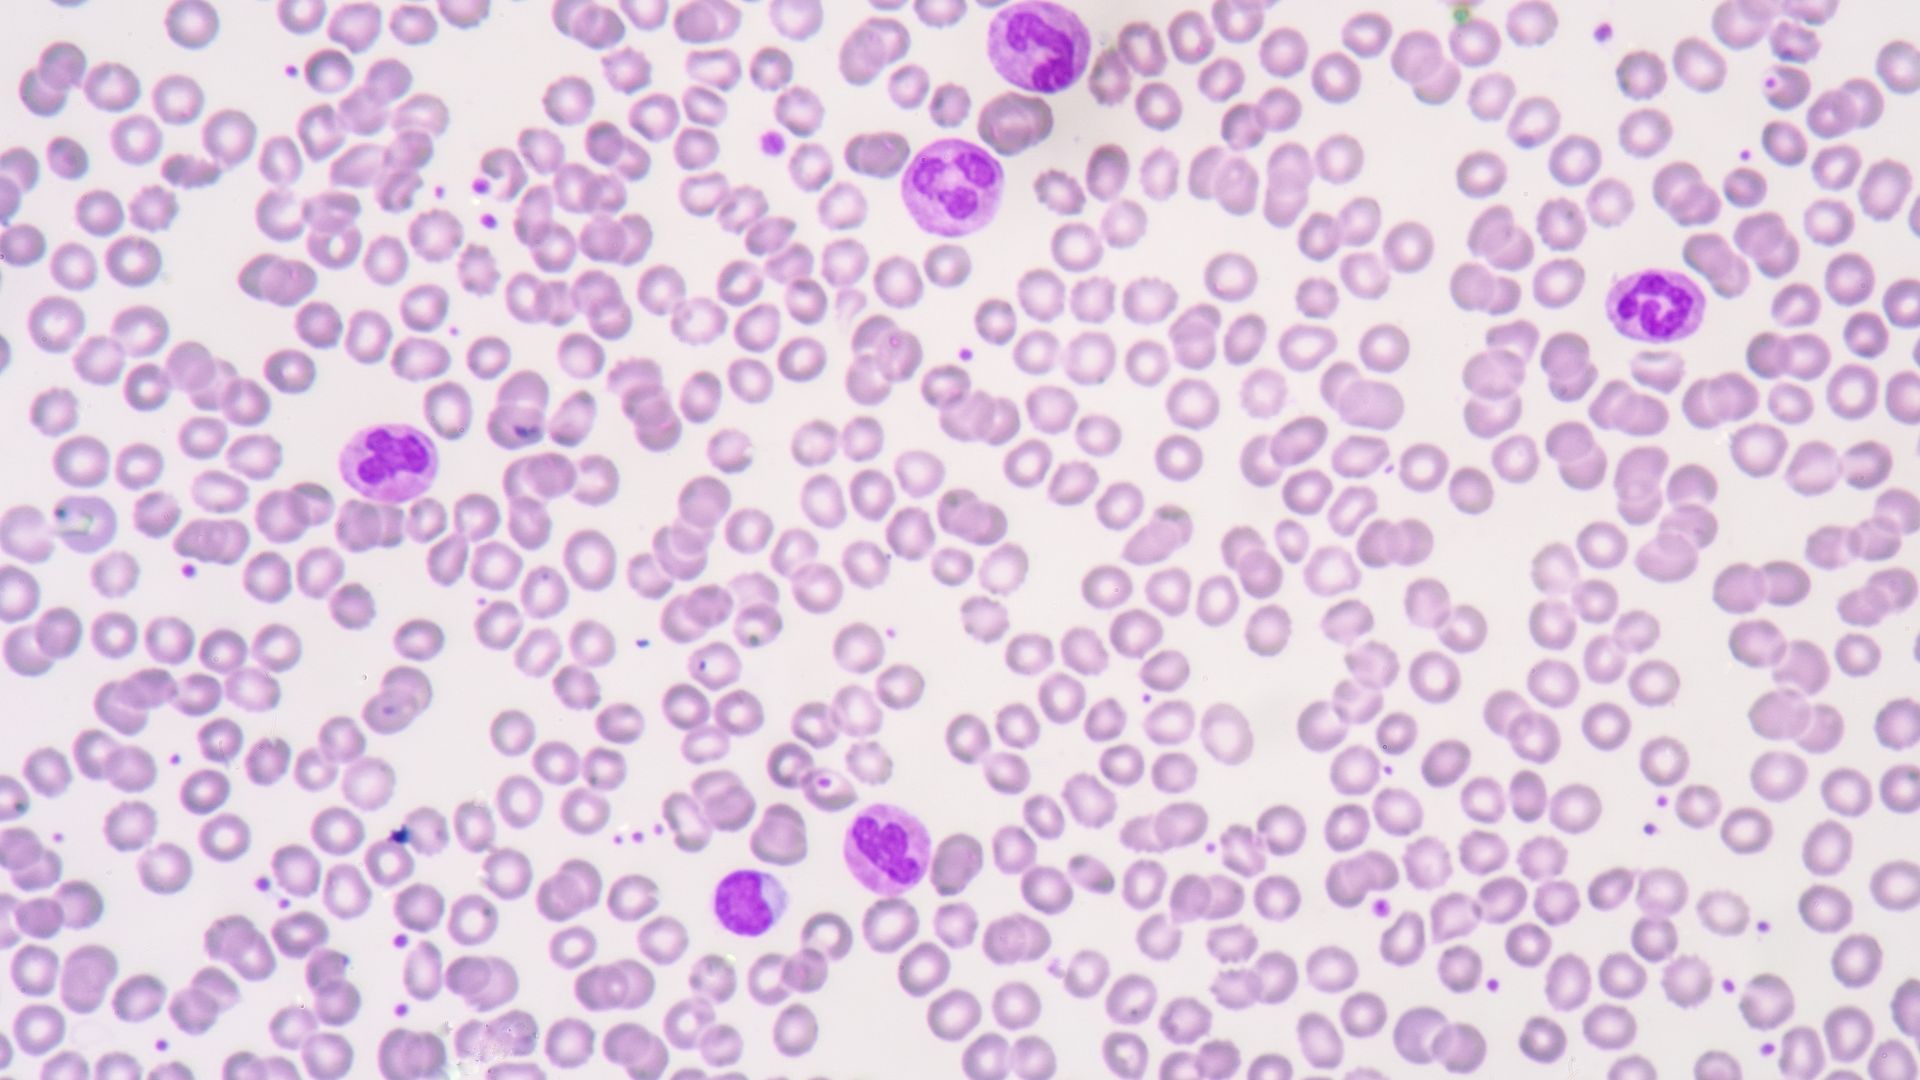

Gene Therapy Trial Targets Seizures That Medicine Can’t Stop
A Rutgers and RWJBarnabas Health neurosurgeon leads testing on whether a one-time treatment can quiet seizure circuits without harming brain tissue A chef named Colton Beschen came to Robert Wood Johnson … Read More